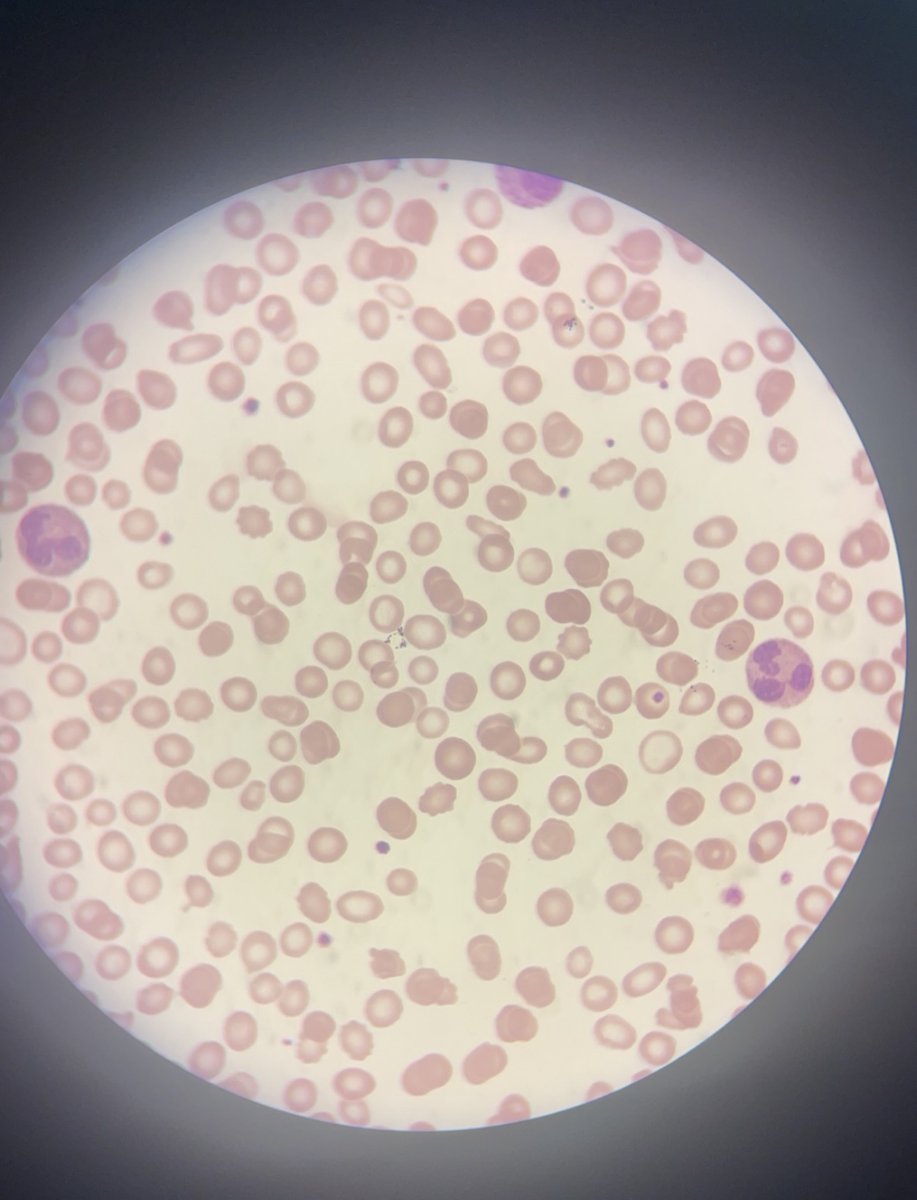
sa90053990's tweet image. تعليقكم على السلايد ؟ 

راح اختار ٥ من التعليقات الصحيحه يحصلون على كورس الهيماتولوجي مجاني ✨

مركز العلوم السريرية للتدريب
@CSTC_2000
( من هنا.... تبدأ .... تكتشف .... تستمر )
عاجل 🔴📢 ينتهي عرض التسجيل ب ٣٣ ريال غداً الخميس الساعة ٩ مساء. (Specific Topics) يوجد شهادة اتمام و حضور ✅ 🔗رابط التسجيل: forms.gle/7bTa4CfF5r4qwG… بإمكانك التواصل واتس للمساعده بالتسجيل او الاستفسار :0530143715 #مركز_العلوم_السريرية_للتدريب

تعليقكم على السلايد ؟ راح اختار ٥ من التعليقات الصحيحه يحصلون على كورس الهيماتولوجي مجاني ✨
Identical twins with differences in aging signs ✨ We will discuss about it 👍
(Specific Topics) يوجد شهادة اتمام و حضور ✅ 🔗رابط التسجيل: forms.gle/7bTa4CfF5r4qwG… بإمكانك التواصل واتس للمساعده بالتسجيل او الاستفسار :0530143715 #مركز_العلوم_السريرية_للتدريب

What types of worms are these?🧐 What diseases can they cause?😥
(Specific Topics) يوجد شهادة اتمام و حضور ✅ 🔗رابط التسجيل: forms.gle/7bTa4CfF5r4qwG… بإمكانك التواصل واتس للمساعده بالتسجيل او الاستفسار :0530143715 #مركز_العلوم_السريرية_للتدريب

متاح التسجيل في ورشة مكافحة العدوى و السلامة ( اونلاين ) .. يوجد شهادة اتمام و حضور ✅ عدد بسيط و يتم الاكتفاء بعدد المسجلين ✨ رابط التسجيل: forms.gle/LvsXDK6LyfAMd7… بإمكانك التواصل واتس للمساعده بالتسجيل او الاستفسار :0530143715 #مركز_العلوم_السريرية_للتدريب

بما ان الان وقت انتشار الانفلونزا، جهزت لكم بعض المعلومات حول الفايروس ، كيف يحدث المرض و ما هي الأشياء المساعدة للفايروس؟ طيب اخذت اللقاح المضاد للإنفلونزا و لكن أصبت بها فوراً 🤧🤒 ؟ لذلك وضحت في النهاية ما هي العوامل الي يعتمد عليها اللقاح ، في النهاية استعرضت بالجدول بعض…

رابط التسجيل 👇🏻 forms.gle/Fz1BYAE1UK2Xyd… بإمكانك التواصل واتس للمساعده بالتسجيل او الاستفسار :0530143715 #مركز_العلوم_السريرية_للتدريب @basimbyg2

ما شاء الله من اجمل المحاضرات كانت مع طلاب نادي بادرة للبيئة المميزين ، الشكر موصول إلى عمادة شؤون الطلاب و كل من ساهم في إنجاح هذه المحاضره ♥️
And more ✨👇🏻 forms.gle/Fz1BYAE1UK2Xyd… بإمكانك التواصل واتس للمساعده بالتسجيل او الاستفسار :0530143715 #مركز_العلوم_السريرية_للتدريب

في ذكرى يومنا الوطني، نحمد الله على ما تحقق من إنجازات في بلادنا الغالية، ووحدة وطنية قامت على الشريعة الإسلامية والعدل.
للإطلاع على المواضيع المتاحه👇🏻 drive.google.com/file/d/1dJqfu9… رابط التسجيل 👇🏻 forms.gle/Fz1BYAE1UK2Xyd… #مركز_العلوم_السريرية_للتدريب

بدأ عرض اليوم الوطني ⏳🇸🇦 اي ٤ كورسات من اختيارك ب ٩٥ ريال فقط 🫡 فرصه لدعم و تعزيز السيرة الذاتية بشهادات حضور لمواضيع مميزه و مفيده ✨ جميع هذي الكورسات مسجله يتم ارسالها بعد التسجيل خلال ٢٤ ساعه ،،، يوصلك رابط الحضور للكورس مسجل و شهادة الحضور و الإتمام ايميل . رابط…

كل عام ونحن بإلهامك نسارع الخطى نحو المستقبل دمت قائدنا وملهمنا دائما 🤍 #مركز_العلوم_السريرية_للتدريب

فوق ان الاسعار مخفضه ، جبت لكم كود خصم 25% صالح لمدة يومين على الثلاث مواضيع هذي 👇🏻✨ الكود : See25 واتس : 0530143715 #مركز_العلوم_السريرية_للتدريب
للإطلاع على باقي المواضيع المتاحه👇🏻 drive.google.com/file/d/1dJqfu9… رابط التسجيل 👇🏻 forms.gle/Fz1BYAE1UK2Xyd… #مركز_العلوم_السريرية_للتدريب



من أهم الكورسات الي ممكن تحصلون عليها 💪🏻 فقط ب 15 ريال ✨ رابط التسجيل: forms.gle/9FHsmdWSZJqF1n… واتس : 0530143715 #مركز_العلوم_السريرية_للتدريب

عينة بول تحت الماكروسكوب ظهر هذا المنظر 👇🏻 ١) ايش هذا ؟ ٢) انديكيشن ل ايش ؟ الي يجاوب صح بيحصل على دورة مكافحة العدوى مجاني ✨💕

متاح محتوى بنك الدم مجااااني ،،، بإذن الله مفيد في (SLLE ,ASCP) فالكم التوفيق ، لا تنسونا من دعواتكم و ممكن تتواصلون واتس للحصول عليه : 0530143715 #مركز_العلوم_السريرية_للتدريب

جبت لكم كود خصم 15٪ ✨ صالح لمدة يومين فقط على كورس PRIMER DESIGN FOR PCR, AND DNA LIBRARY, NEXT GENERATION 🧬SEQUENCING (NGS) الأكثر طلب و الأعلى تسجيل ✅ الكود : B150 تواصلوا واتس للتسجيل : 0530143715
للإطلاع على باقي المواضيع المتاحه👇🏻 drive.google.com/file/d/1dJqfu9… رابط التسجيل 👇🏻 forms.gle/Fz1BYAE1UK2Xyd… #مركز_العلوم_السريرية_للتدريب



جبت لكم كود خصم 15٪ صالح لمدة 24 ساعة فقط ، على اي كورس من اختيارك … الكود : S15 تواصلوا واتس للتسجيل : 0530143715
للإطلاع على باقي المواضيع المتاحه👇🏻 drive.google.com/file/d/1dJqfu9… رابط التسجيل 👇🏻 forms.gle/Fz1BYAE1UK2Xyd… #مركز_العلوم_السريرية_للتدريب



United States เทรนด์
- 1. Sedition 176K posts
- 2. Cheney 87.6K posts
- 3. Lamelo 6,651 posts
- 4. Texans 20.6K posts
- 5. Seditious 96.3K posts
- 6. Constitution 116K posts
- 7. Commander in Chief 54.3K posts
- 8. First Take 47.3K posts
- 9. Seager 1,273 posts
- 10. Coast Guard 24.1K posts
- 11. Jeanie 2,073 posts
- 12. UCMJ 10.2K posts
- 13. TMNT 4,322 posts
- 14. Trump and Vance 37.2K posts
- 15. Last Ronin 1,692 posts
- 16. UNLAWFUL 79K posts
- 17. Cam Newton 4,662 posts
- 18. Mark Walter 1,531 posts
- 19. Shayy 14.8K posts
- 20. Dizzy 7,335 posts
Something went wrong.
Something went wrong.






















































































